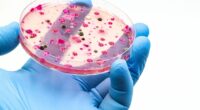
Urgent warning issued as killer fungus spreads round world - 'becoming more infectious'

The driver involved in the tragic accident that left renowned boxer Anthony Joshua injured and claimed the lives of two of his close friends may soon face legal consequences for reckless driving, as we have learned.
After being released from the hospital, the local driver hired for the journey has provided a statement to the police. CSP Benjamin Hundeyin, a spokesperson for the Nigerian Police Force, confirmed to the Daily Mail, “Anthony Joshua’s driver has been discharged from the hospital, and he is currently giving his statement.”
Meanwhile, authorities in Nigeria have issued a wanted notice for the driver of the truck also implicated in the incident. It is reported that this individual fled the scene immediately following the crash.
As the New Year unfolds, former world heavyweight boxing champion Anthony Joshua remains in one of Nigeria’s top hospitals, with his parents by his side.
The devastating accident occurred on the Lagos-Ibadan Expressway in Makun, Nigeria, when the vehicle carrying Joshua and his friends collided with a stationary truck. The crash resulted in the deaths of Joshua’s longtime friends, Sina Ghami and Kevin Latif Ayodele.
Joshua’s long-time friends Sina Ghami and Kevin Latif Ayodele were killed in the crash after the car ploughed into a stationary truck on the Lagos-Ibadan Expressway in Makun, Nigeria.

Joshua was in a horrific car crash that killed two of his best friends in Nigeria on Monday

The driver of the car could be prosecuted, according to reports in the Nigerian media

Joshua pictured with friends Latif Ayodele (centre) and Sina Ghami who both died in the crash
Babatunde Akinbiyi, a spokesperson for Ogun State’s Traffic Compliance and Enforcement Agency, confirmed a preliminary investigation into the crash has been conducted.
The investigation has concluded that the car had been ‘speeding’, with the front tyre on the passenger side then bursting, causing the driver to lose control.
‘From the preliminary investigation that was conducted, definitely there was overspeeding on the part of the SUV Anthony Joshua was travelling in,’ Akinbiyi told reporters.
‘In the course of that, the front tyre on the passenger side burst.
‘That led to loss of control before the vehicle now swerved and rammed into the stationary truck that was parked. There was excessive speed.’
After the fatal road collision, Joshua was rushed to the Duchess International Hospital in Lagos, which has been rated the best private hospital in Nigeria for the past two years.
Local police told Daily Mail Sport that Joshua is ‘stable’ and suffered only ‘minor’ injuries, although there are fears they could be more severe than publicised.
Sources say that Joshua is set to remain in hospital for at least a couple more days while he continues to recuperate.


Joshua will spend New Year’s Eve at one of Nigeria’s best hospitals as he continues to recover from a car crash that killed two of his friends (pictured above after the road incident)

Joshua is being treated at the Duchess International Hospital (pictured above) in Nigeria

The Duchess, named as Nigeria’s best private hospital, says it offers patients one-to-one care for 24-hours a day and has ensuite bathrooms
An eyewitness told Punch newspaper: ‘It was a two-vehicle convoy: a Lexus SUV and a Pajero SUV.
‘Joshua was seated behind the driver, with another person beside him. There was also a passenger sitting beside the driver, making four occupants in the Lexus that crashed. His security detail was in the vehicle behind them before the crash.
‘Other eyewitnesses and I began the rescue and flagged down oncoming vehicles to assist. A few minutes after the crash, officials of the Federal Road Safety Corps arrived.’
Footage taken at the roadside showed the boxer grimacing in agony as he was moved from the wrecked vehicle into a police cruiser.
Nigeria’s president revealed on Monday that Joshua’s mother Yeta Odusanya had rushed to his bedside at the hospital after being informed of the crash.
The luxury hospital boasts an elite service dubbed the Harley Street Practice, located on the sixth floor, which offers Duchess Royal Suites for VIP patients.
Patients receive one-to-one care 24-hours a day and have access to medical personnel and hospitality staff. They also receive gourmet meals fully catered to their taste.
The basic packages for the Royal Suite with ensuite bathroom facilities starts at £2,000.
A representative of Joshua issued a statement on Monday evening confirming the deaths of the boxer’s two team members and ‘close friends’.

Footage taken at the roadside showed the former world champion boxer grimacing in agony

Joshua’s mother Yeta Odusanya, pictured with him in 2019, has rushed to her son’s bedside
The spokesman said: ‘It is with the deepest and most profound sadness that we confirm, following a road traffic accident in Lagos, Nigeria earlier today, the death of Sina Ghami and Kevin “Lateef” Ayodele.
‘Both were close friends and integral members of Anthony’s team.
‘We respectfully ask that space and privacy be given to the families at this time while they process this truly shocking and devastating news.
‘Anthony sustained injuries in the accident and was taken to hospital for checks and treatment, he is in a stable condition and will remain there for observation.
‘No further information will be made available at this time.’
The crash, which occurred at midday local time, came just 10 days after Joshua defeated Jake Paul in Miami.
As reported by the Daily Mail on Monday, Joshua had been visiting family in Nigeria as part of a one-week holiday, with a view to resuming training ahead of a fight in late March, most likely in Saudi Arabia against the kickboxer Rico Verhoeven, prior to his proposed showdown against Fury in September or October.